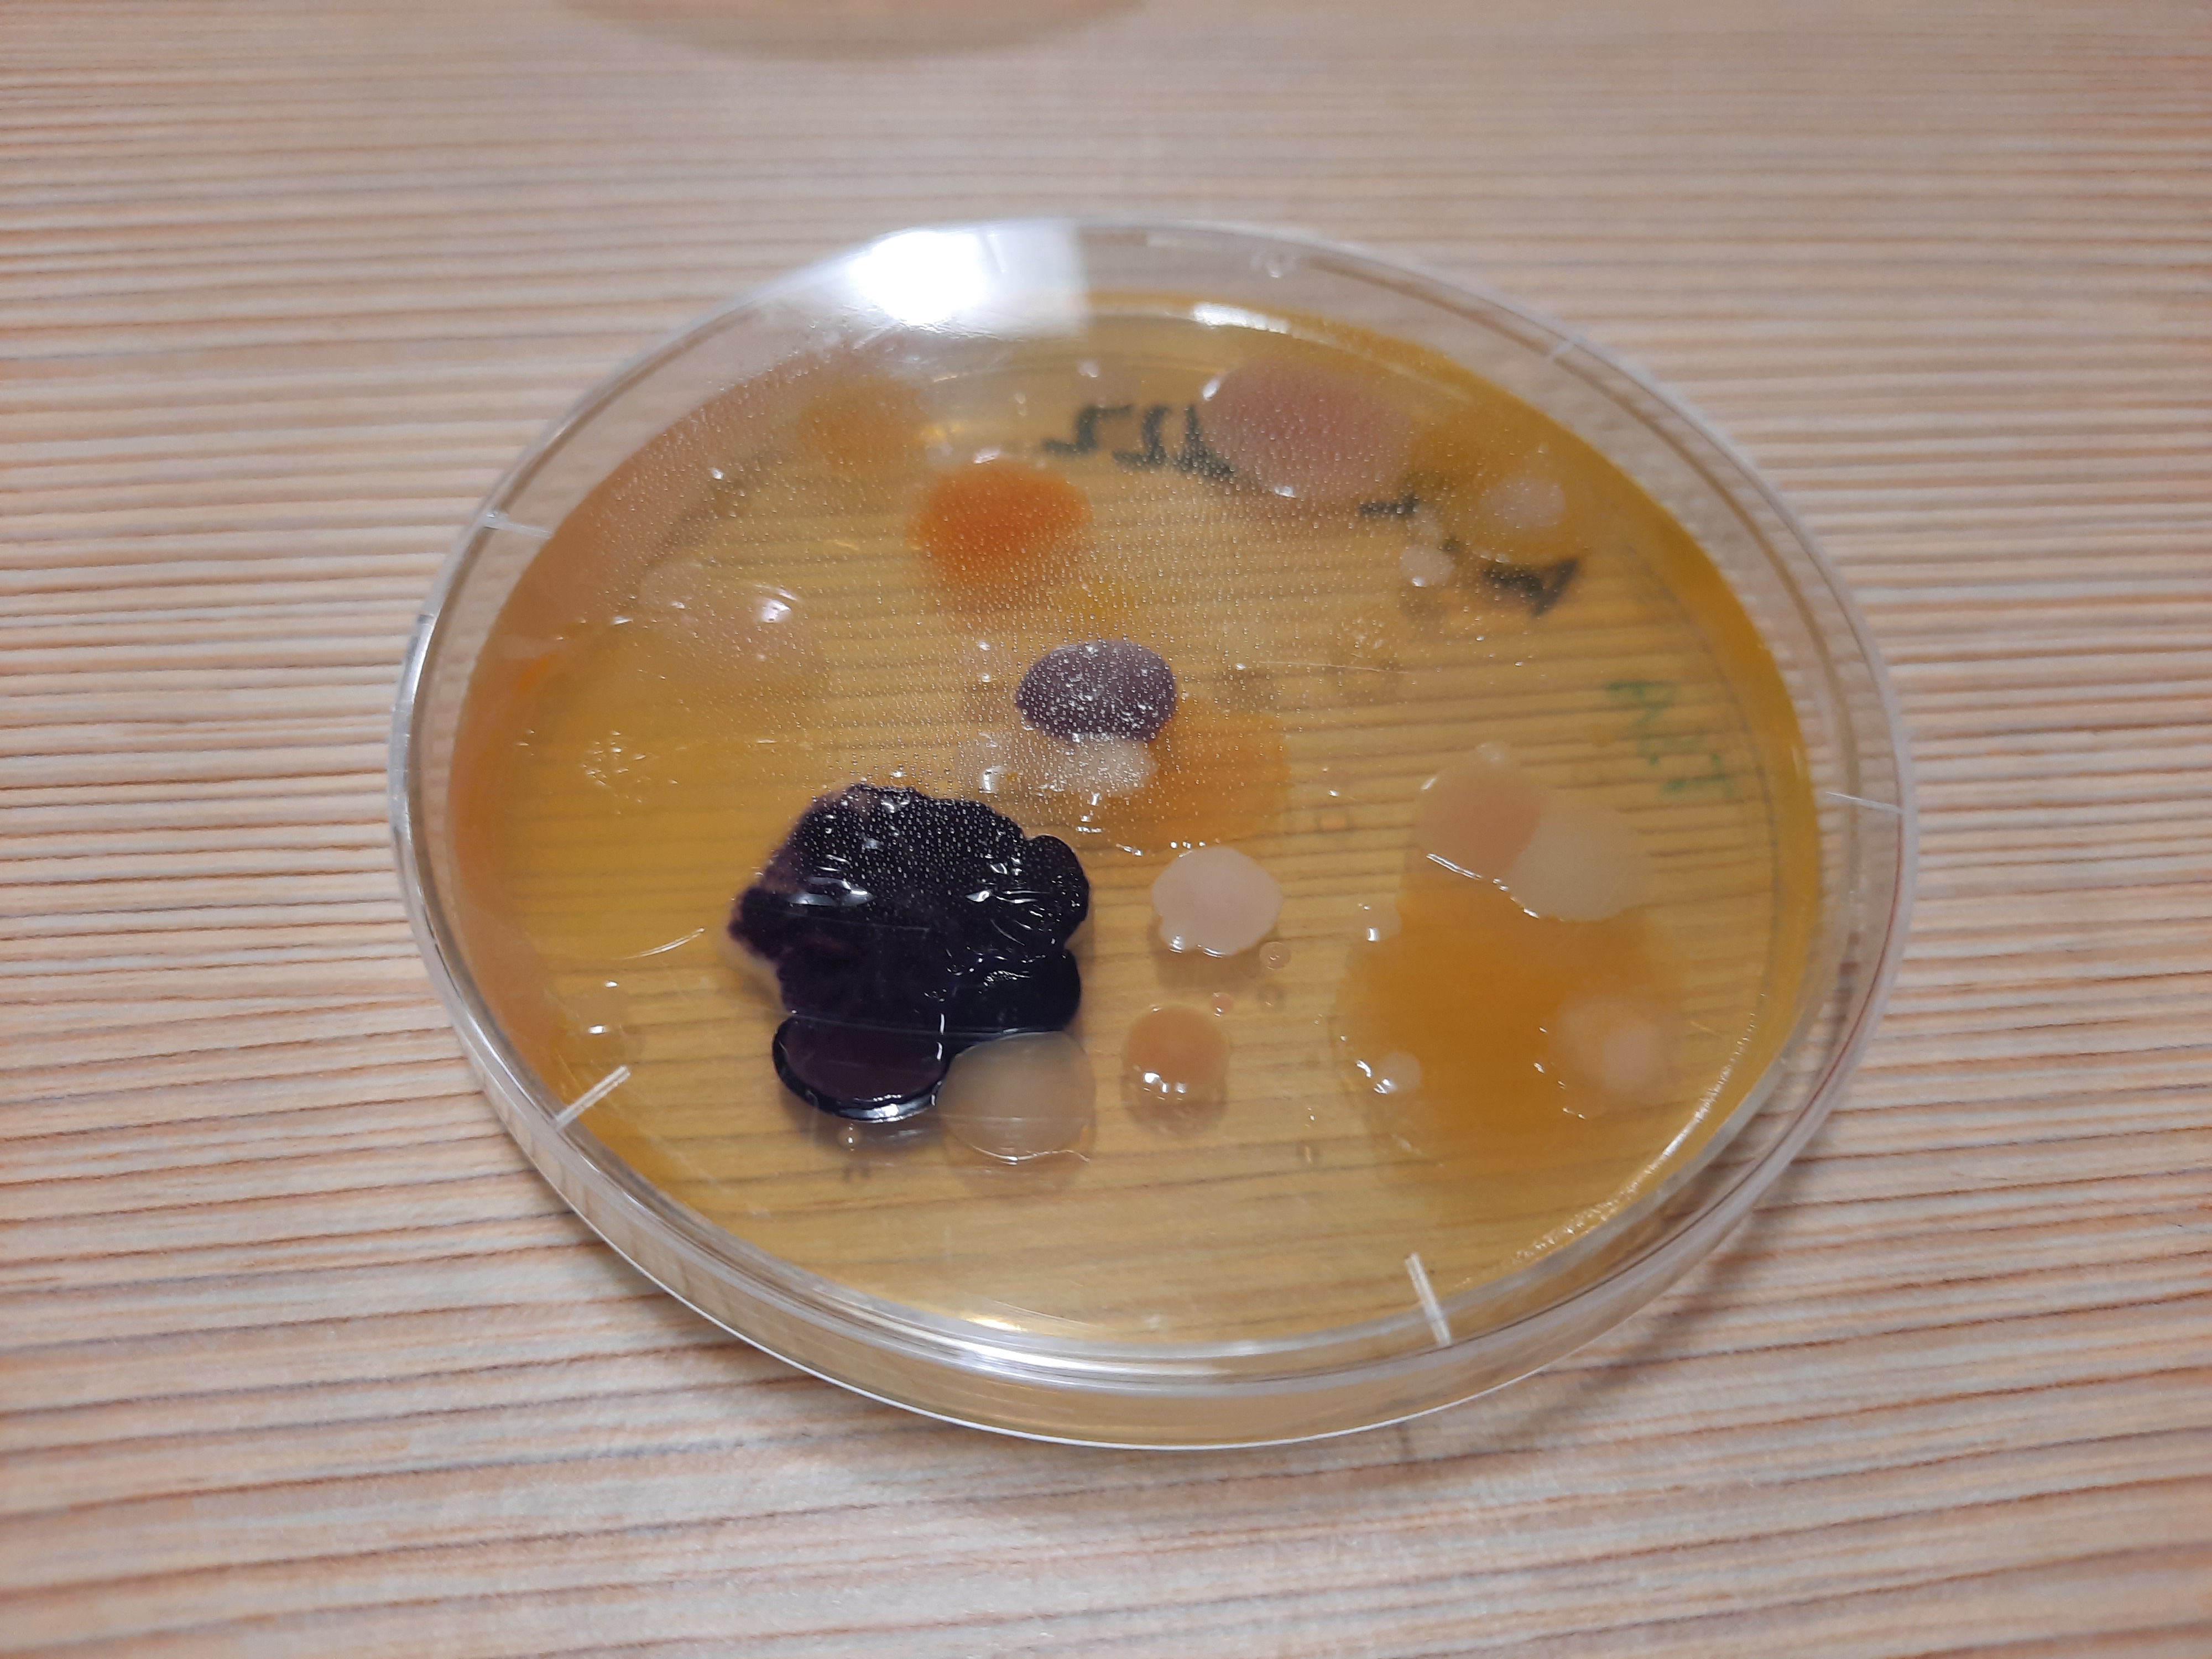

DON'T NEED OUR SPECIALIST INDUSTRY KNOWLEDGE & SERVICES RIGHT NOW, BUT LIKE TO STAY IN TOUCH WITH US? HERE'S HOW.

We've got the specialist capabilty, knowledge and experience to address your technical challenges, help realise opportunities and create value for your company.
Whether you're a multinational, large, medium, small business or start-up, we can help!
And if you'd really love to access all of our ~75 years' experience in applied microbiology to achieve your strategic vision get in touch - we'd love to partner with your business!
WHEN YOU REALLY* NEED TO KNOW WHAT'S HAPPENING, WE OFFER SPECIALIST TESTING SERVICES
ARE YOU LOOKING FOR...
IDENTIFICATION SERVICES FOR BACTERIA, YEAST OR MOULD?
MICROBIOLOGICAL COMMUNITY PROFILING OF SAMPLES?

HEAT RESISTANT MOULD TESTING OF MATERIALS OR PRODUCTS?

PROCESS VALIDATION OR CHALLENGE TESTING?

LEARN MORE...
Are you still picking so-called 'representative' colonies and identifying a small fraction of the organisms appearing on your plates, one-at-a-time, all the time wondering if you're picking the 'right' colonies to understand what's happening? Send your plates to us - we can identify ALL of the bacterial, and yeast and mould colonies appearing on an agar plate or petrilm ALL at the same time. With guaranteed standard 5 day TAT, or in as little as 24 - 48 hours for time critical samples, we can help you get to the bottom of your investigations sooner and better!
LEARN MORE...
Are you waiting, waiting, waiting for spoiled products or bad ferments to be cultured so that you can diagnose the cause of the problems and figure out if there are any safety concerns, while you lose sleep wondering if you will need to dump, withdraw or recall a product. If it's taking too long for you to get your results, costing serious $$$ while your product remains on hold or you out-of-stock, get in touch with us. You can send us your samples or factory swabs and we'll identify everything that's there, without needing to culture. And we'll help you understand what the results mean for your product or process.
LEARN MORE...
If you're worried that your current testing lab might be under-or-over-reporting HRM we can help. Our team have been testing for HRM
in all sorts of raw materials and finished goods for more than 20 years! we've got all the skills and equipment to test for HRM and to confirm and correctly identify any presumptive HRM
we recover from your raw materials or finished goods.
Or ask your current testing lab to forward any presumptive HRM to us for confirmation and identification - we know that it's a special skill we have!
LEARN MORE...
Do you need to validate a new process or product? We can offer industry standard and bespoke shelf-life testing, challenge testing and surrogate validation for cold, warm and hot fill beverages and sauces, preserved ready-to-eat foods including plant-based foods, thermal processing of nuts and desserts and more. We also offer validation of factory sanitisers and disinfectants. We hold a comprehensive collection of challenge test surrogates and spoilage organisms and hold a collective experience of > 75 years to help you validate your process or product.
*FAST, COMPREHENSIVE, STATE-OF-THE-ART TESTING,
WITH EXPERT INTERPRETATION THAT REALLY HELPS YOUR BUSINESS

APPLIED MICROBIOLOGY & MICROBIOMICS
About Quantal
FOR EDUCATORS
Pioneering education
CONNECT WITH QB

We acknowledge the Bidjigal people of the Darug Nation who are the traditional owners of the land on which we work,
and pay our respects to Elders past, present and emerging.
Copyright © 2025 Quantal Bioscience – 28/10 Gladstone Rd Castle Hill NSW 2154 Australia – (+61) 2 8000 3720
PO Box 6225 Baulkham Hills NSW 2153 Australia contact@quantalbioscience.com





